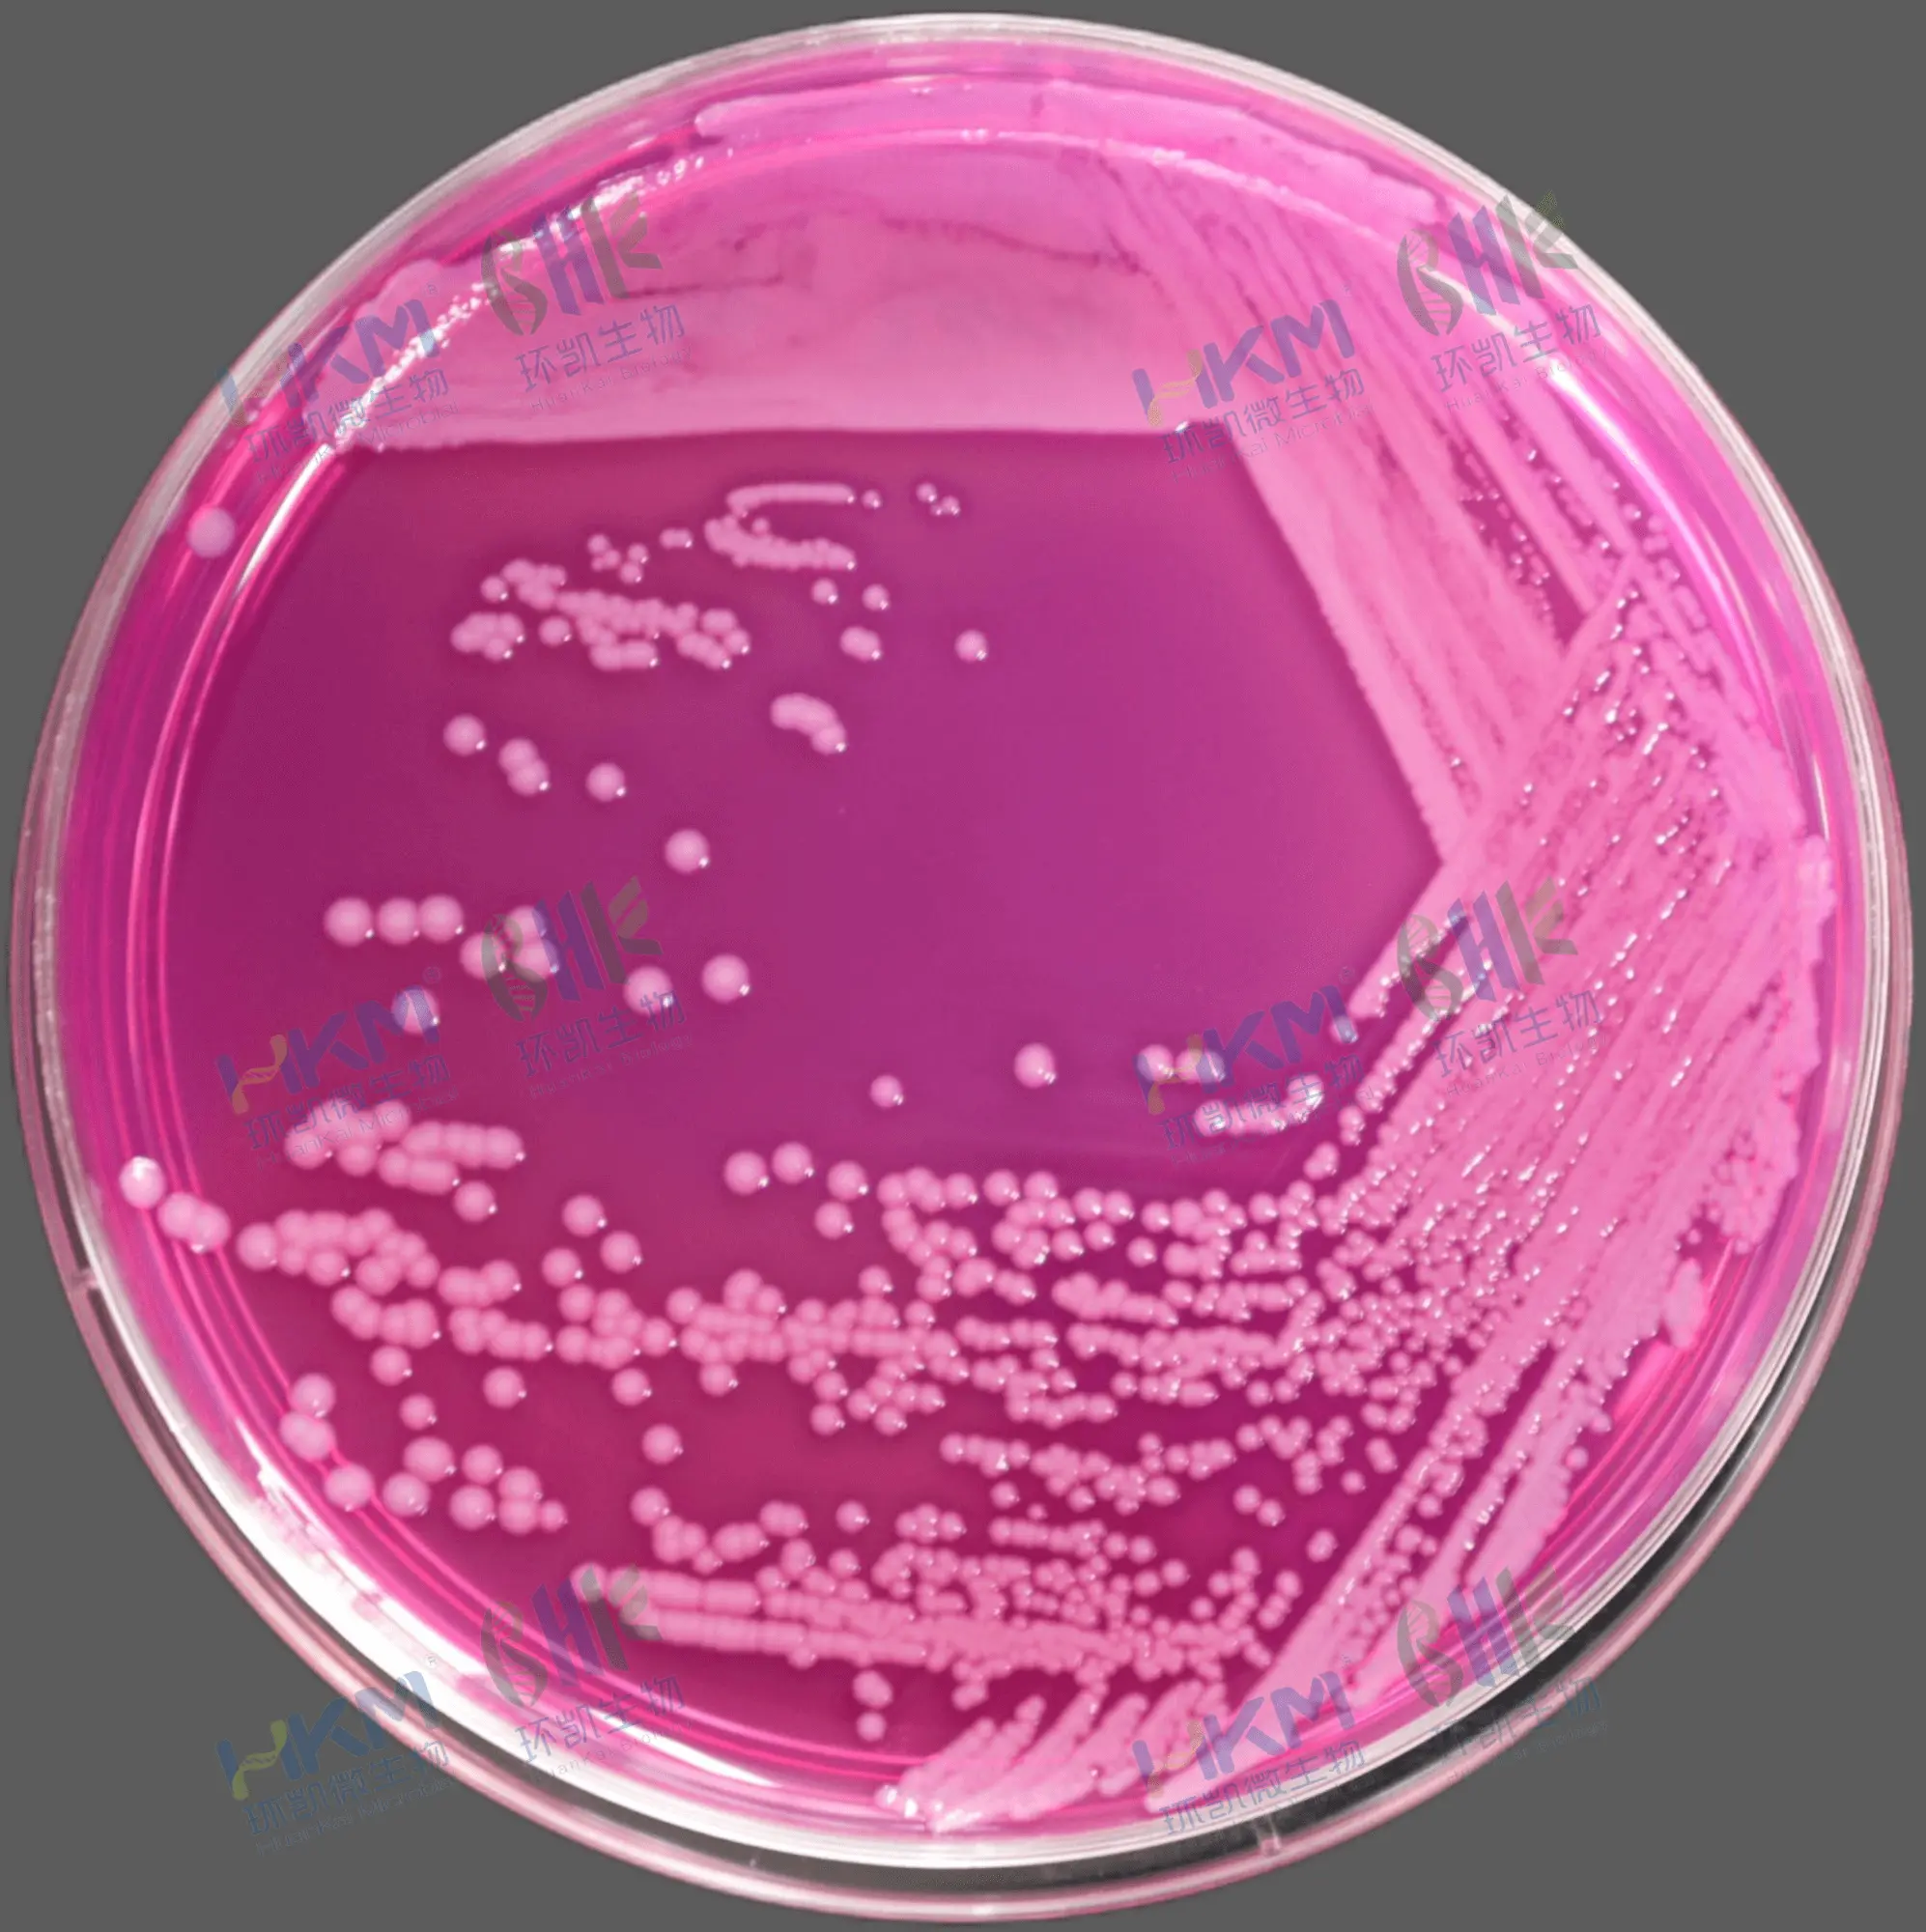
神秘伯克霍尔德菌 CMCC(B) 23010
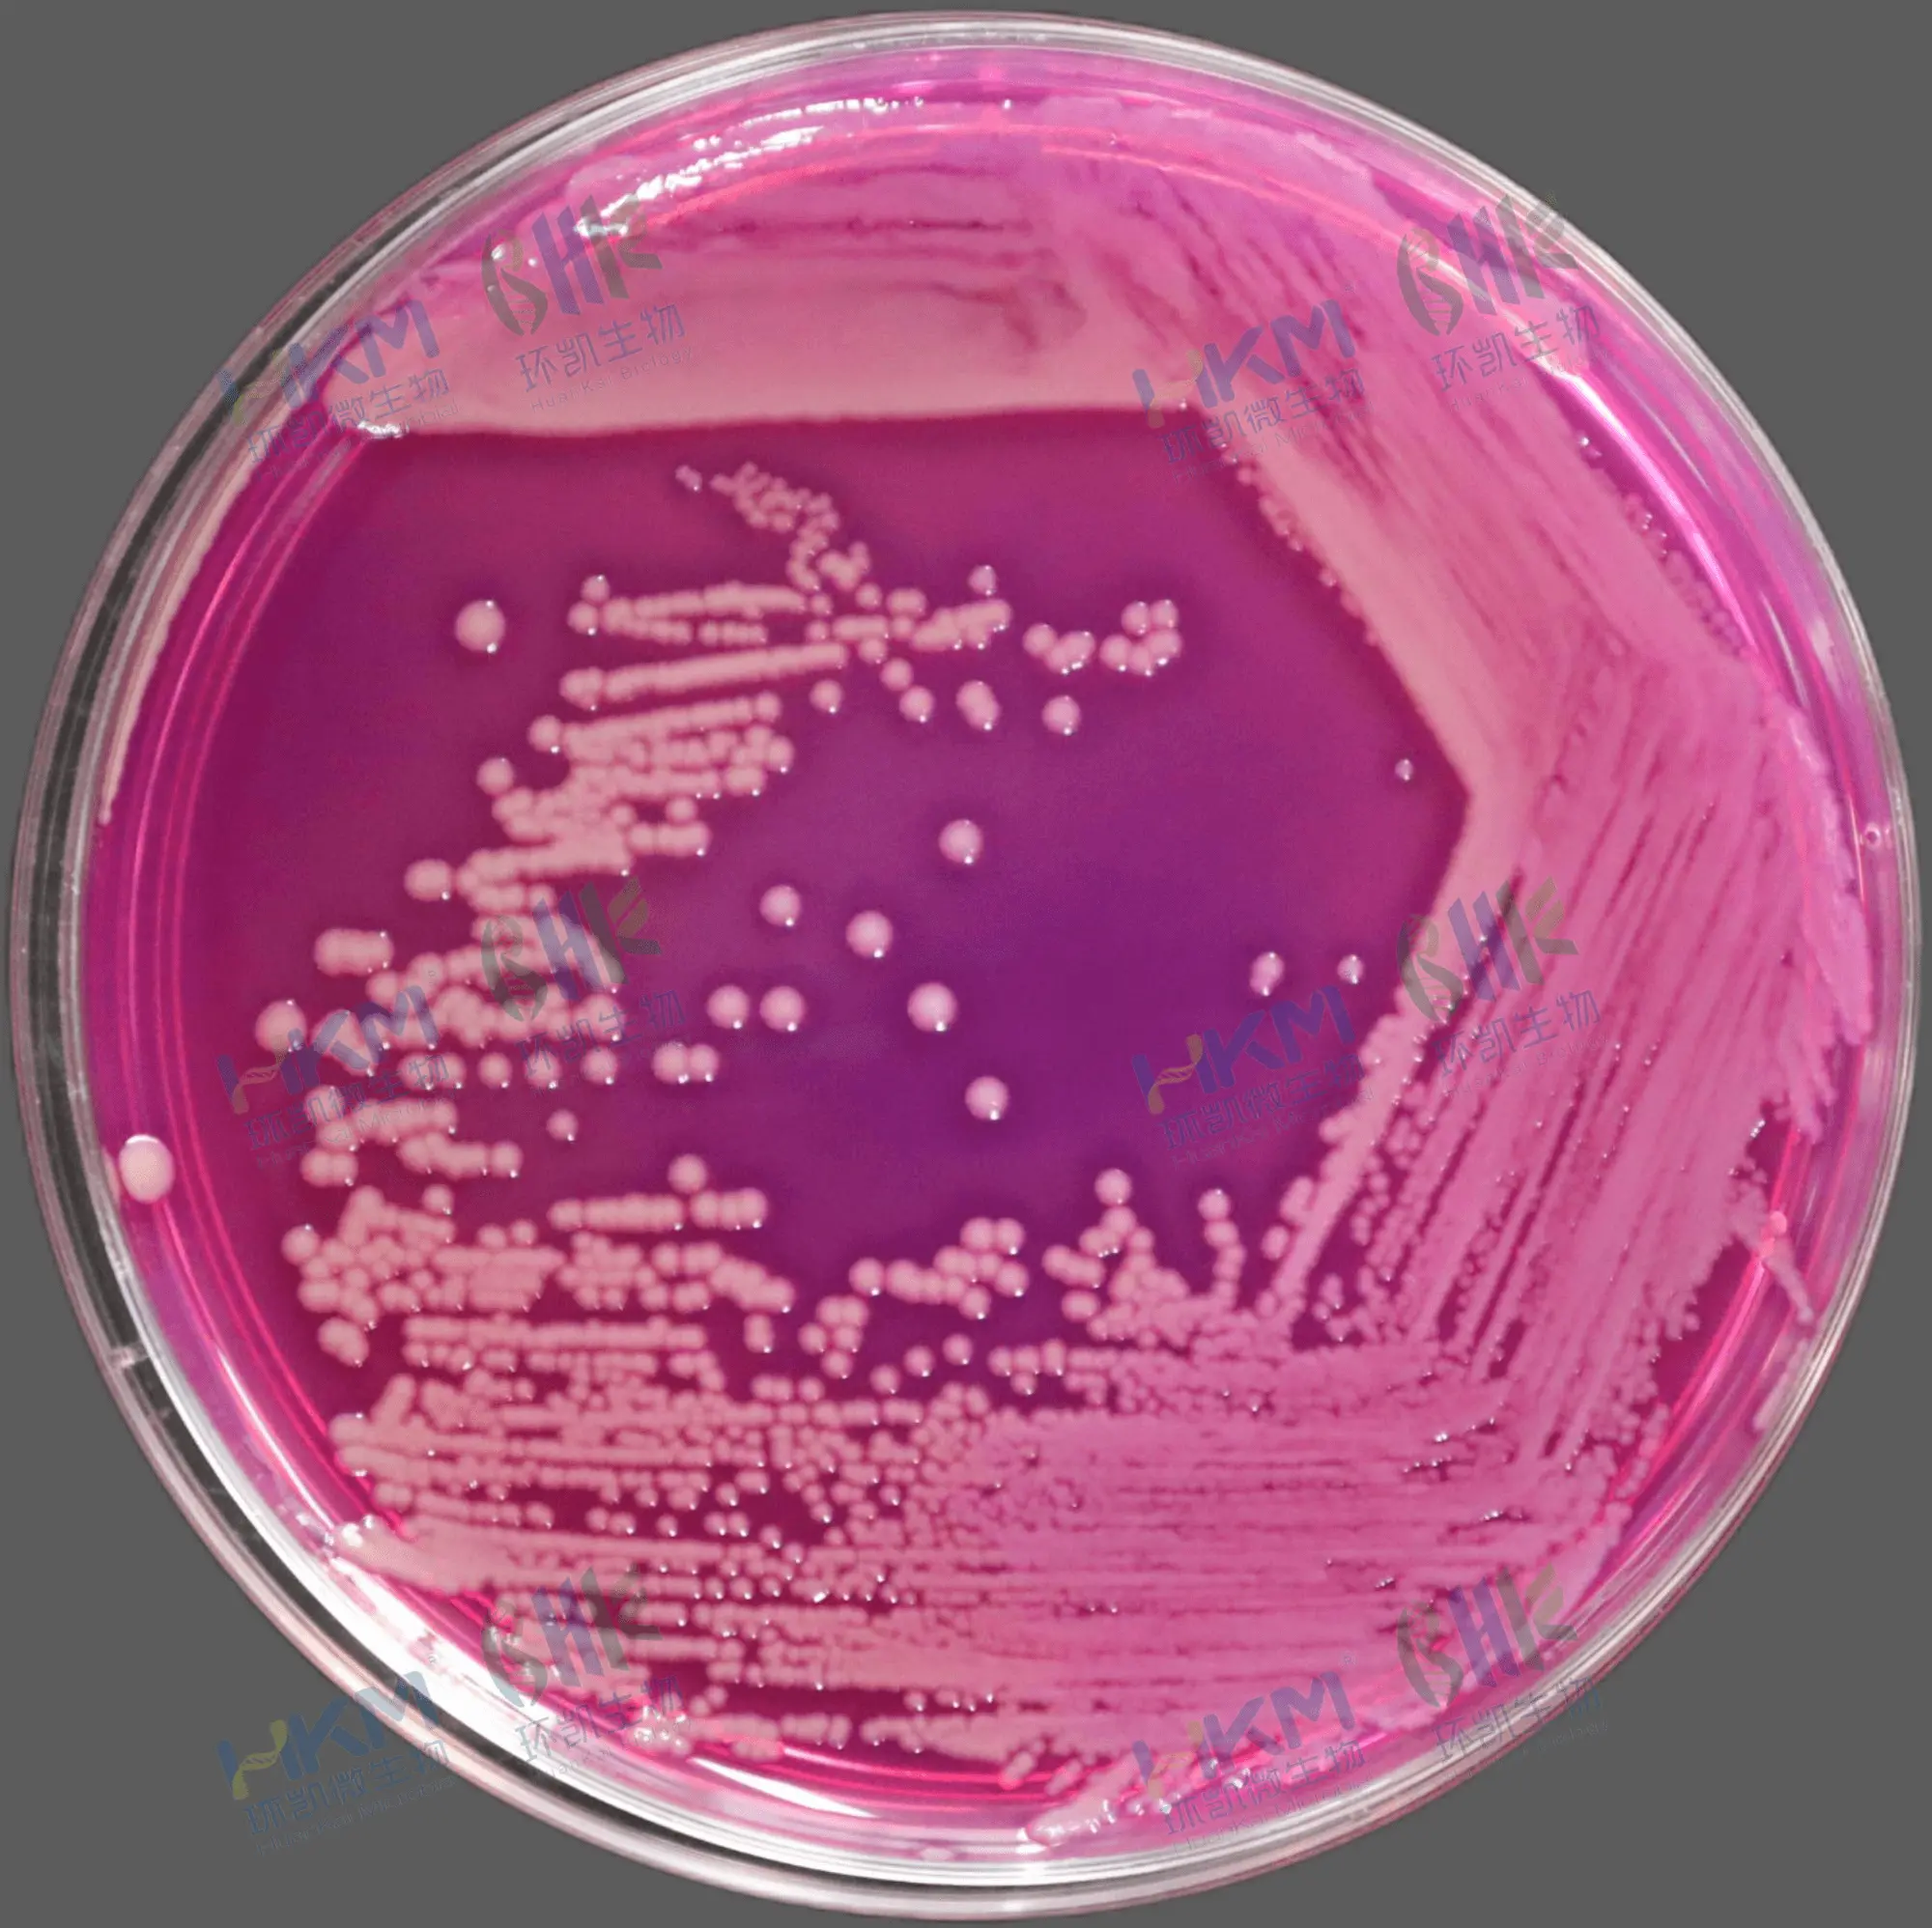
新洋葱伯克霍尔德菌 CMCC(B) 23006
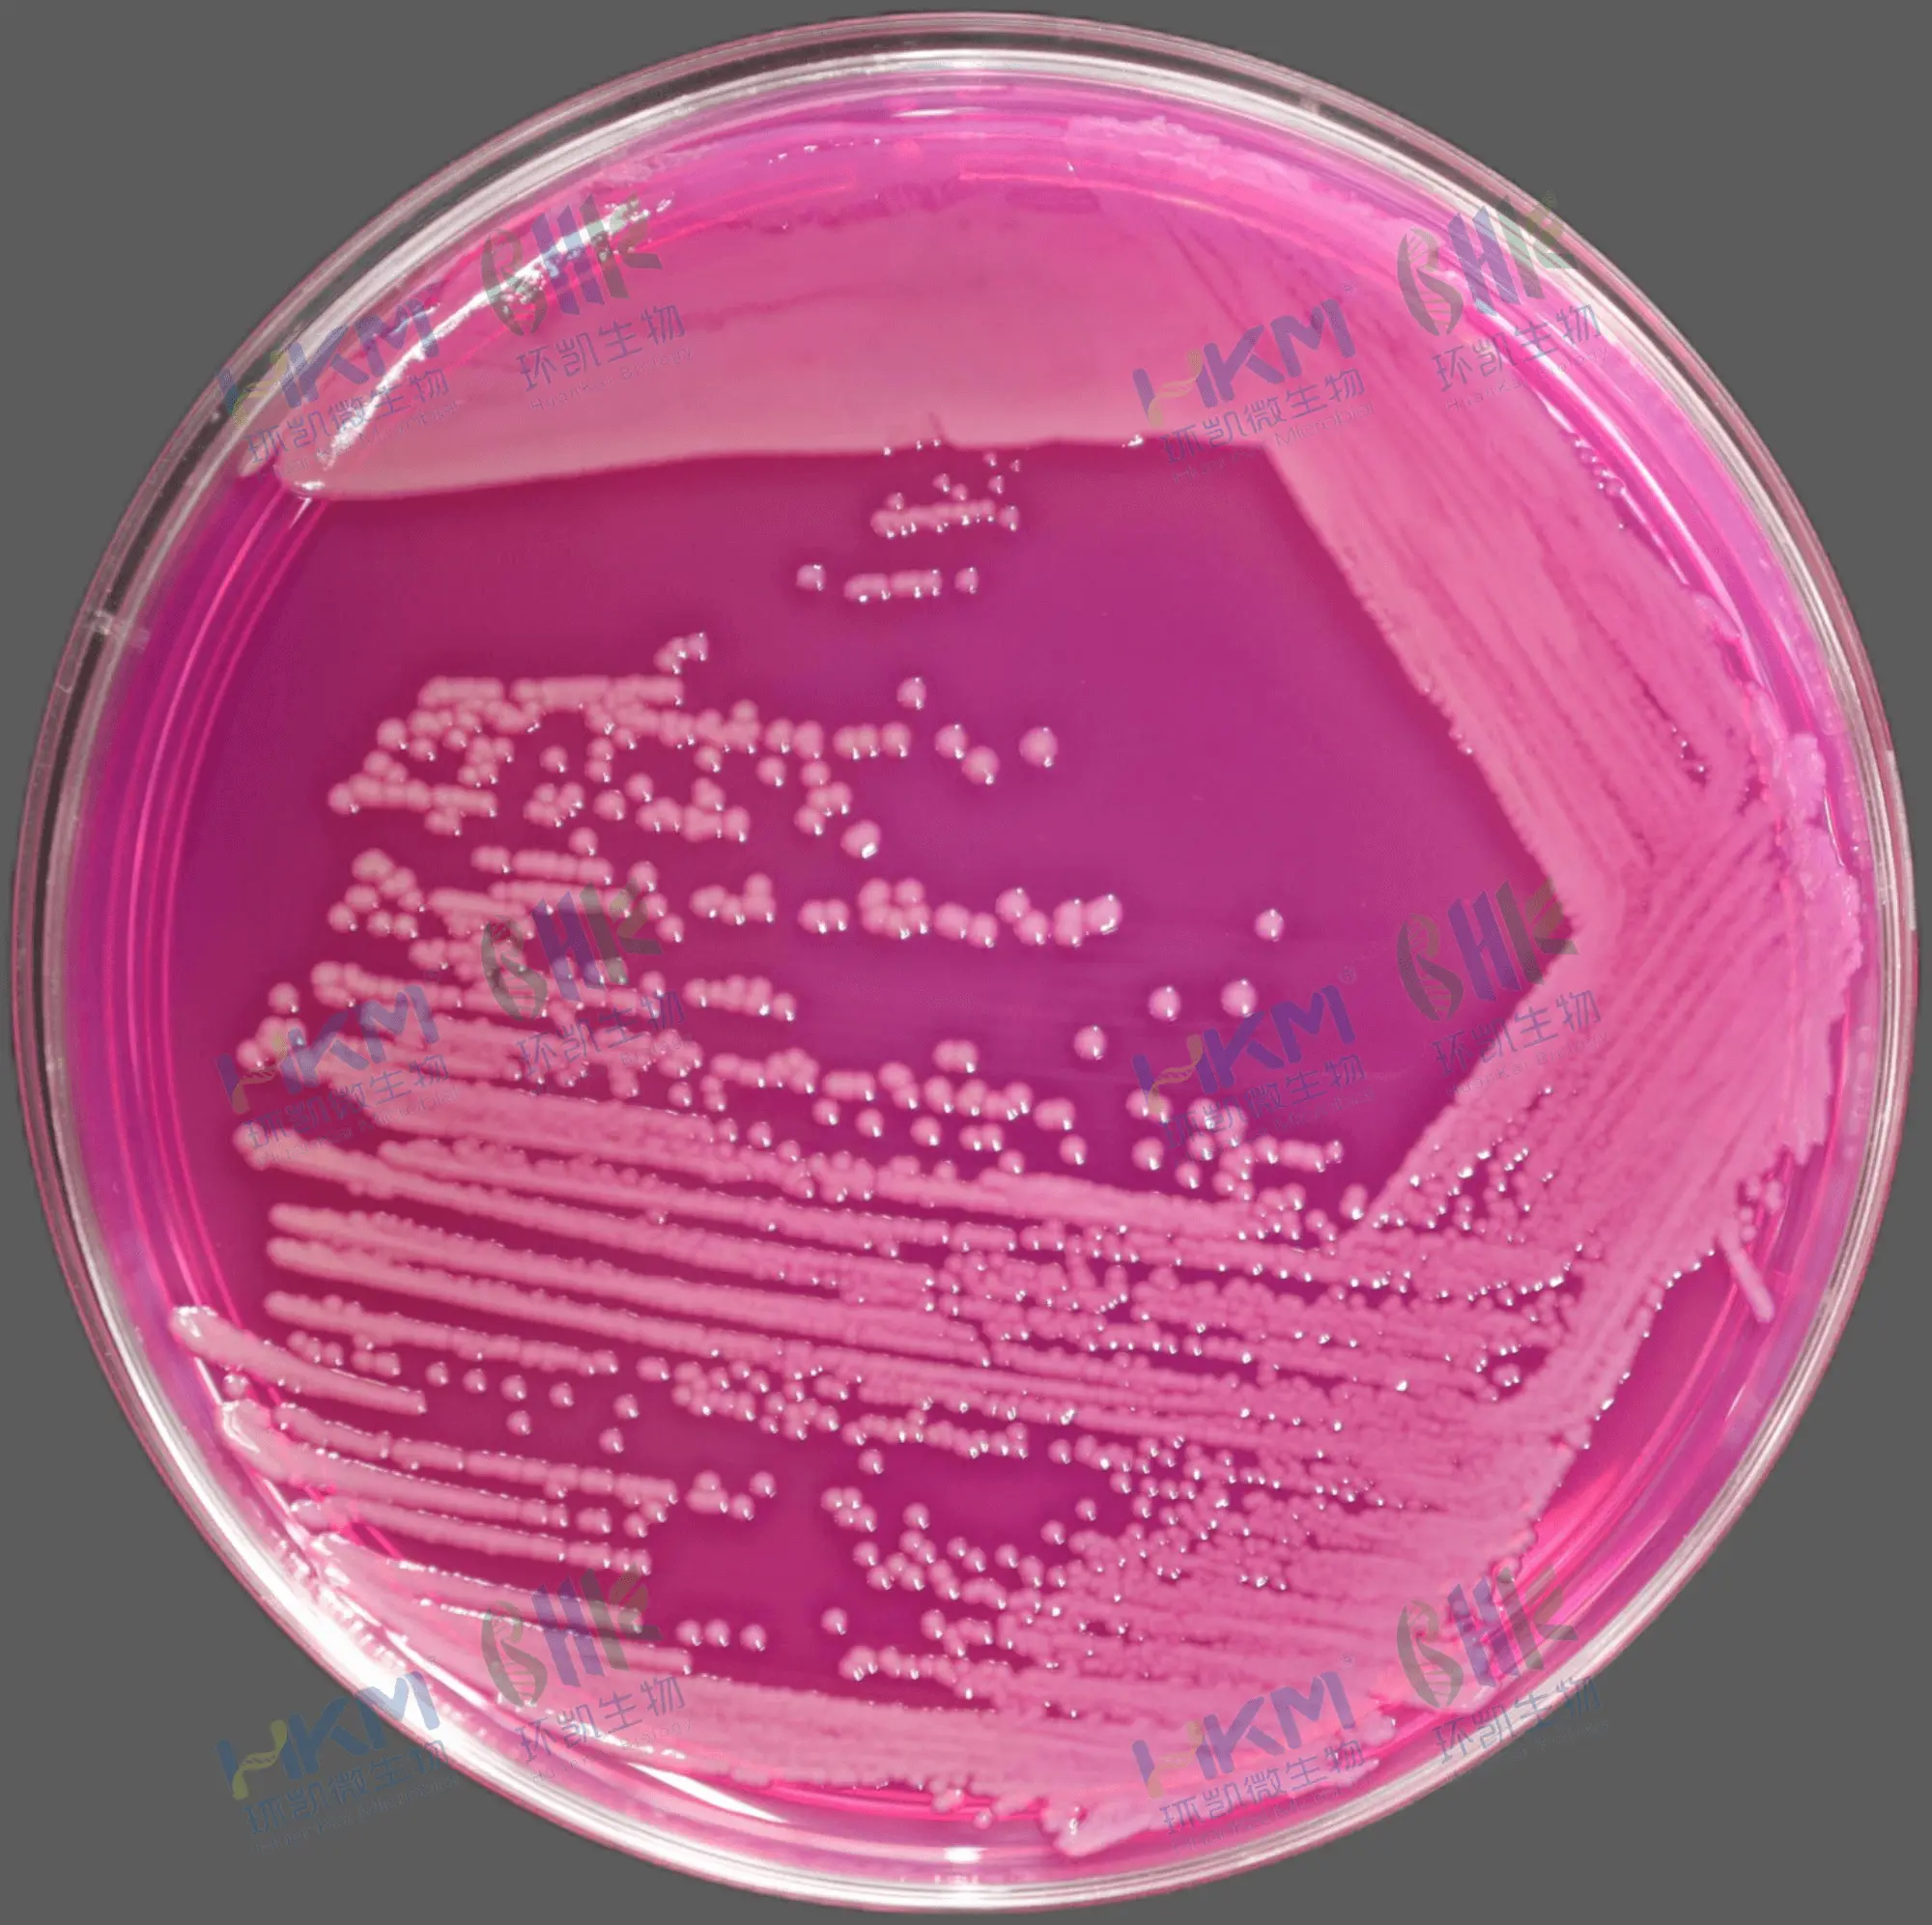
洋葱伯克霍尔德菌 CMCC(B) 23005

2025版药典来袭,洋葱伯克霍尔德菌检验如何应对?
发布时间:2025-03-21 浏览次数:8621
2025版中国药典已发布,预计2025年10月实施,对药品微生物检验提出了更高要求。新药典针对水基类固体/液体和半固体制剂,如:栓剂/凝胶/喷雾/口服混悬剂等产品容易受到洋葱伯克霍尔德菌群(Burkholderia cepacian complex)(Bcc)的污染问题,及时新增洋葱伯克霍尔德菌群检查法<1109>,规定了非无菌制剂及原辅料中Bcc的检测流程,包括供试液制备和增菌培养/选择和分离培养及结果判断。面对新标准,我们需提前准备,应对新指标新方法所带来的工作量和挑战。
为此,环凯微生物推出洋葱伯克霍尔德菌群检查法系列培养基和即用型定量菌株,并结合菌落特征识别技巧,为药品微生物实验室提供全方位的解决方案,助力各实验室轻松应对挑战。
1、培养基系列产品

2、定量菌株系列产品

3、洋葱伯克霍尔德菌群菌落特征识别
关键是了解洋葱伯克霍尔德菌群生物学特性和洋葱伯克霍尔德菌群选择性琼脂培养基(BCCSA)的原理。
▶ 洋葱伯克霍尔德菌群生物学特性:一种严格需氧、不产孢子、革兰氏阴性杆菌,氧化酶试验阳性或阴性,触酶试验阳性,多数菌株利用蔗糖和丙酮酸钠作为碳源,对多黏菌素天然耐药、42℃不生长等。
▶ 洋葱伯克霍尔德菌群选择性琼脂培养基(BCCSA)配方原理:“胰蛋白胨、酵母提取物”作为氮源以及提供维生素、生长因子;“蔗糖和丙酮酸钠”作为碳源;“氯化钠”维持均衡的渗透压;磷酸二氢钾为缓冲剂和pH调节剂;酚红为pH指示剂,按照酚红的变色指示范围:在 pH6.4~8.2时由黄变红,该培养基初始pH为 6.2±0.2,培养基颜色为黄色(如图1所示);接种后微生物生长代谢产生碱性产物时,使培养基的pH值升高,颜色变为红色,培养基接种前后颜色变化明显易于观察;结晶紫抑制革兰氏阳性菌的生长;多粘菌素B、庆大霉素能够抑制包括大肠埃希菌、铜绿假单胞菌在内的大部分革兰氏阴性杆菌。万古霉素对葡萄球菌属包括金葡菌和凝固酶阴性葡萄球菌中甲氧西林敏感及耐药株、各种链球菌、肺炎链球菌及肠球菌属等多数革兰阳性菌均有良好抗菌作用。琼脂作为培养基的凝固剂。
洋葱伯克霍尔德菌群在BCCSA上利用其碳源和氮源等营养成分生长代谢得到碱性产物,使用得培养基pH升高,颜色由初始得黄色向橘红色/玫红色转变。因此,洋葱伯克霍尔德菌群在BCCSA上培养后,形成的菌落为圆形,灰白、灰粉色或(土)黄色,菌落周围的培养基为橘红色或玫红色(如图2所示)。
| | |
| 神秘伯克霍尔德菌 CMCC(B) 23010 | 新洋葱伯克霍尔德菌 CMCC(B) 23006 | 洋葱伯克霍尔德菌 CMCC(B) 23005 |
| 图2 洋葱伯克霍尔德菌群菌在BCCSA培养基上生长的典型菌落特征 | ||
参考文献:余萌;王似锦;曹蕊;马仕洪;洋葱伯克霍尔德菌群(Bcc)的选择和分离培养基研究[J];中国药事;2022年07期.






